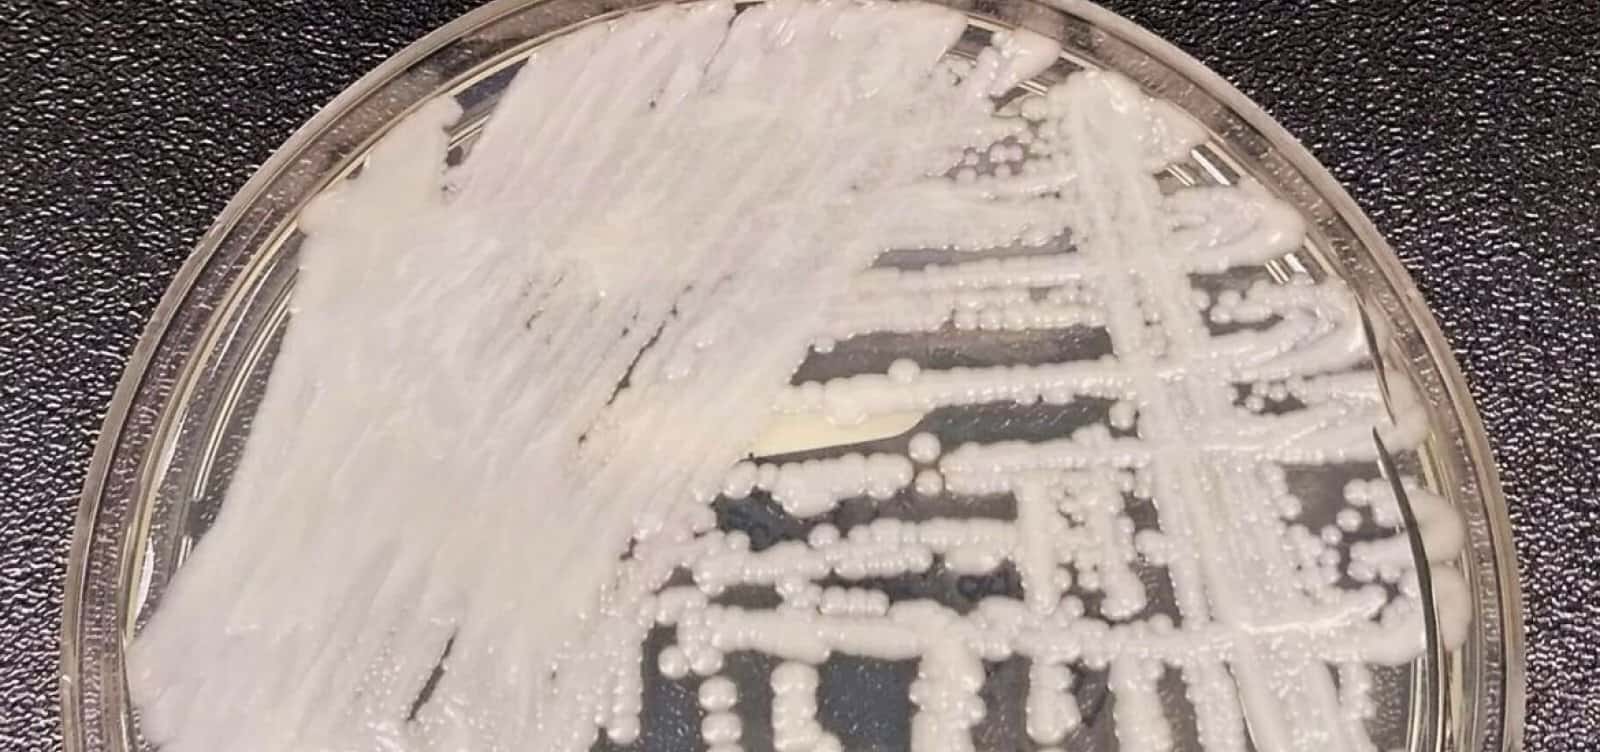
Foto: CDC / Dr. Leanor Hailey

O dólar à vista caía frente ao real nesta quinta-feira (29), refletindo a reação dos investidores a dados econômicos do Brasil e do exterior, além

O presidente da Câmara dos Deputados, Hugo Motta (Republicanos-PB), afirmou nesta quinta-feira (29), que quer construir, em parceria com o governo federal, uma alternativa ao

O ministro da Fazenda, Fernando Haddad, rebateu nesta quinta-feira (29) as críticas que vem recebendo pela decisão do governo de elevar as alíquotas do Imposto

Durante a operação da Polícia Civil em que o cantor Marlon Brandon Coelho Couto Silva, o MC Poze do Rodo, foi preso, um dos carros de